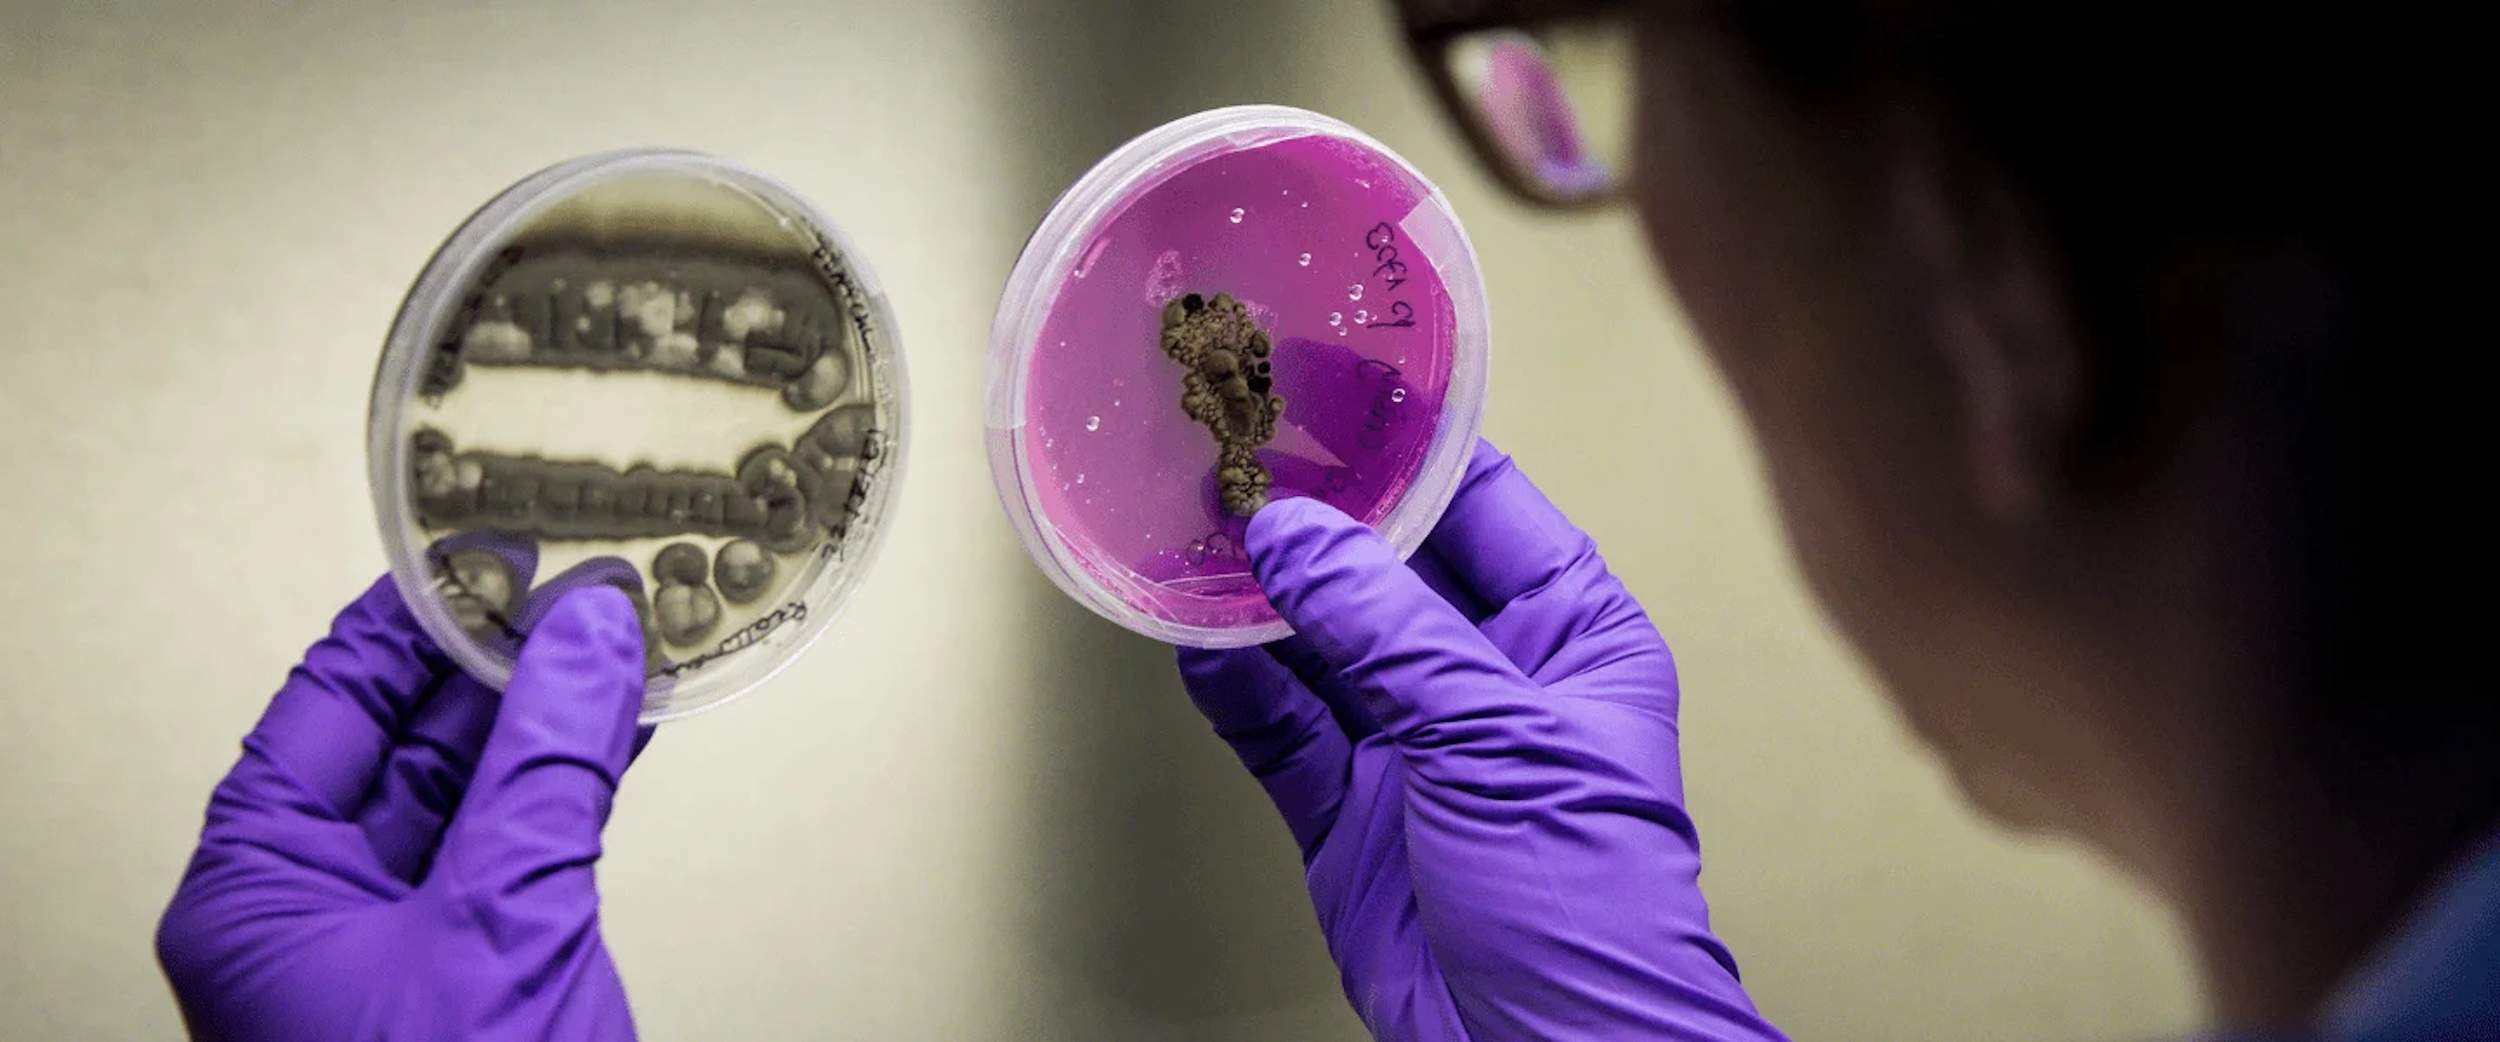
¿Quién forma el comité de seis expertos en bioseguridad que liderará la auditoría de la peste porcina?

Ya se conocen los nombres de los seis expertos en bioseguridad y peste porcina que formarán el comité que auditará las instalaciones, los equipamientos, los protocolos y los procedimientos para averiguar si el virus que ha provocado el brote en Catalunya ha salido de un laboratorio científico, y si es así, si está relacionado con el centro del IRTA-CReSA o los laboratorios próximos a la zona cero donde se encontraron los primeros casos, en Cerdanyola del Vallès. El consejero de Agricultura, Ganadería, Pesca y Alimentación de la Generalitat, Òscar Ordeig, ha anunciado la composición de este comité de especialistas, que estará coordinado por el director del IRTA, Josep Usall, y que estará formado por la doctora Laura Pérez, jefa del área animal y seguridad biológica del CISA (Centro de Investigación en Sanidad Animal), organismo dependiente del INIA-CSIC, que ejercerá como presidenta del comité y coordinadora científica. Su presencia en el comité es relevante, puesto que el CISA es el laboratorio de referencia europeo mencionado estos días, y la doctora Pérez es quien ha liderado el primer estudio genético del virus, que determina que la cepa del brote en Catalunya no es la misma que el que hace años que corre por Europa y que pertenece a un grupo genético nuevo, que es similar a una cepa (Georgia 2007) que se utiliza en estudios de laboratorio para el desarrollo de vacunas experimentales contra esta enfermedad.
El resto del comité de expertos está integrado por el doctor veterinario Gorka Aduriz, especialista en Peste Porcina Africana (PPA) que trabaja como jefe del Área de Sanidad Animal en Neiker-BRTA (Instituto Vasco de Investigación y Desarrollo Agrario), el virólogo veterinario Massimo Palmarini, que actualmente es director del Departamento de Virología en el Erasmus Medical Centre (Erasmus MC) de Róterdam; el biólogo y veterinario Gonzalo Pascual, director Técnico y Jefe del Área de Seguridad Biológica y Biocontención en el Instituto de Salud Carlos III (ISCIII); Xavier Abad, jefe de la Unidad de Alta Biocontención y de los laboratorios NBS2 del IRTA-CReSA y la doctora Diana Ramirez, jefa de la plataforma de infraestructuras de producción animal y presidenta del comité ético de experimentación animal del IRTA
“Hemos buscado a los mejores expertos”
“Hemos buscado a los mejores expertos en bioseguridad en laboratorios de alta contención biológica, no estamos hablando de cualquier laboratorio, son laboratorios NBC-2 y NBC-3, por lo tanto, de alta contención biológica, seis 4 externos de diferentes centros, uno del CReSA y otro del IRTA”, ha explicado Ordeig, antes de dar a conocer los nombres de los integrantes de este comité, que ya se reunirá este mismo martes para empezar a trabajar. Ordeig, que no ha descartado que se puedan incorporar más miembros a este comité, que tendrá absoluta "autonomía” y contará con “todos los recursos logísticos y todos los recursos necesarios” para hacer su trabajo. El conseller ha explicado que el comité será el máximo responsable y quien decidirá el plan de trabajo, "analizando los protocolos, las instalaciones, los flujos, y el tipo de muestras muertas y vivas que se utiliza" (...), y por lo tanto "si puede haber potencial riesgo al margen del laboratorio del CReSA”, según ha avanzado Ordeig. “Cuando decidan el qué, deberán hacer una revisión de los espacios físicos, de la cual también serán los responsables”, ha remachado.
No especular y dejar trabajar a los científicos
Sobre la responsabilidad del centro IRTA-CReSA, los centros que serán auditados, Ordeig ha insistido mucho en "no sacar conclusiones precipitadas” ni hacer hipótesis antes de tener datos e información concreta, y ha pedido “prudencia” a la opinión pública y ha mantenido que "tendrán que ser los profesionales y los científicos “y no la política” quienes digan cuáles son estos centros y si es necesario analizarlos. La misma prudencia que ha pedido a la hora de sacar conclusiones sobre el origen del brote. “Esta semana tendremos información muy importante”, tanto en este terreno, como en el de la secuenciación de todos los tipos de virus de PPA “que corren por Europa”, cosa que también puede ayudar a aclarar cuál es el origen del brote y de las “posibles coincidencias” con la "cepa del virus que ha infectado a los jabalíes" de Collserola. El conseller ha recordado que *"hay 29 tipos de virus, y otros no identificados” y que la secuenciación del virus de los animales encontrados y con todos los que se están investigando en los laboratorios “tendremos una información muy fidedigna de posibles coincidencias, pero hoy no las tenemos todavía”. Ordeig ha insistido en que la fuga biológica “todavía es una especulación” y que "son los científicos quienes nos lo tienen que decir. Harán comprobaciones y cruzaremos toda la información”.*
Reapertura del mercado de Corea del Sud
El conseller se ha mostrado satisfecho por la reapertura progresiva de los mercados. Ha citado entre ellos el de Corea del Sur, que supone 113 millones para Catalunya al año, dado que ha aceptado la regionalización en el ámbito de los 20 kilómetros del foco, cosa que no ha hecho China, que mantiene el protocolo de restringir toda la provincia de Barcelona. “Nos interesa mucho Japón (349 millones en exportación de cerdo) y Filipinas (125 millones al año)”, ha apuntado el conseller, como próximos mercados a convencer de que apliquen la regionalización. Ordeig, que ha insistido en que no hay ningún vaciado de granjas (lo que solo se hace cuando los animales dan positivo en la enfermedad, que no es el caso), y ha recordado que hay 55 granjas afectadas y que 35.600 cerdos irán al circuito de comercialización, lo que es seguro “por los mataderos y por la salud”.
La superpoblación de jabalíes, "una asignatura pendiente"
En cuanto a los trabajos para la contención del jabalí, Ordeig ha dicho que se va "por buen camino", y ha repetido que el foco "está "contenido" y que no hay casos positivos fuera del primer radio de 6 km, pero ha insistido en la importancia de "no dar pasos en falso y dar certezas para ir recuperando la normalidad". El conseller ha agradecido nuevamente la "colaboración ciudadana" y su "implicación" para conseguir reducir al máximo las incidencias relacionadas con ciudadanos que no siguen las indicaciones sobre restricciones de movilidad dentro de la zona infectada. Más allá de eso, ha detallado que "el 112 ha recibido "más de 1.500 llamadas" sobre avistamientos de jabalíes vivos o muertos, dato que ha ofrecido como muestra de la implicación de la ciudadanía ante el brote de peste porcina africana. También ha agradecido el trabajo de los "cazadores por la intensificación de las batidas" que se están "para evitar al máximo el riesgo de contagio" y reducir la población de jabalí en zonas donde hay mucha sobrepoblación. El conseller ha asegurado que combatir esta sobrepoblación "es una asignatura pendiente".